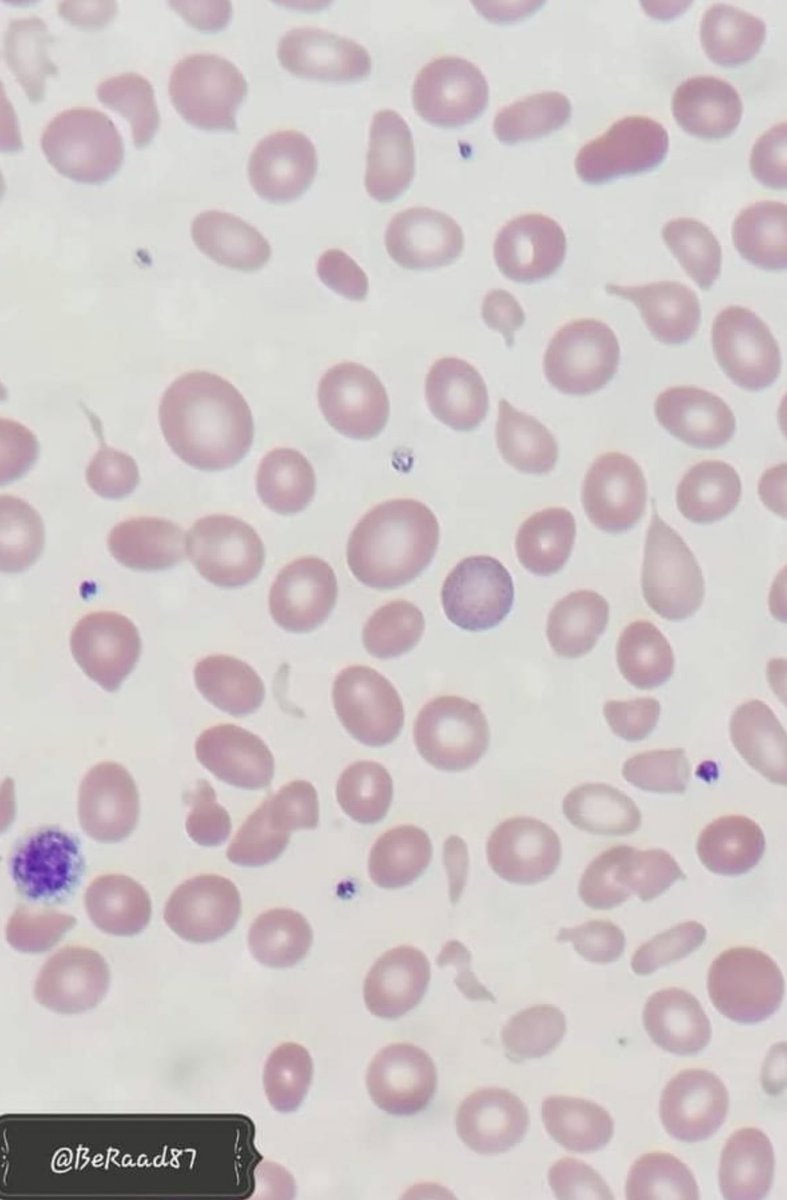

اذا لا يوجد اختلاف كبير بين الاحجام و بالتالي حيكون (RDW) طبيعي بمعني لا يوجد(variation) بين احجام كرات الدم الحمراء
اما اذا بعض كرات الدم الحمراء في نطاق الحجم الطبيعي و اخرى احجامها اصغر او اكبر بشكل ملحوظ فهذا يدل على ان هنالك (variation) بين احجام كرات الدم الحمراء و بالتالي
اما اذا بعض كرات الدم الحمراء في نطاق الحجم الطبيعي و اخرى احجامها اصغر او اكبر بشكل ملحوظ فهذا يدل على ان هنالك (variation) بين احجام كرات الدم الحمراء و بالتالي
يرتفع (RDW)
🤔طيب كيف نحسب (RDW)⁉️
في نوعين لطريقة الحساب
(RDW-SD) او (RDW- Standard deviation) و هذه قيمة بتتقاس مباشرة من على هيستوجرام كرات الدم الحمراء (عند 20% من كرات الدم) اي ان الجهاز بيشوف اصغر حجم تم قياسه ل 20% من كرات الدم الموجودة و بيشوف اكبر حجم تم قياسه ل 20% من
🤔طيب كيف نحسب (RDW)⁉️
في نوعين لطريقة الحساب
(RDW-SD) او (RDW- Standard deviation) و هذه قيمة بتتقاس مباشرة من على هيستوجرام كرات الدم الحمراء (عند 20% من كرات الدم) اي ان الجهاز بيشوف اصغر حجم تم قياسه ل 20% من كرات الدم الموجودة و بيشوف اكبر حجم تم قياسه ل 20% من
كرات الدم الموجودة و بكل سهولة يحسب الفرق بينهم و بكذا بيكون القيمه (RDW-SD) و الرنج الطبيعي له (39-46 fL) و منطقيا طبعا كلما كان في (variation) فى الاحجام كل ما كان المنحنى اوسع و بالتالي قيمه (RDW-SD) اكبر
او (RDW-CV) (RDW- Coefficient of Variation) و دي نسبة مئوية بنحسبها
او (RDW-CV) (RDW- Coefficient of Variation) و دي نسبة مئوية بنحسبها
بقسمة (1 SD of RBC volume) على (MCV) ثم الضرب في 100 للحصول على نسبة مئوية و الرنج الطبيعي له (11-15 %)
ملحوظه: (1 SD of RBC volume) او ما يعرف (Standard deviation of MCV) هي المسافة تحت الكيرف على ارتفاع (68.2%) من قاعدته (يعني عند الحجم الا يمثله 68% من الخلايا الحمراء)
ملحوظه: (1 SD of RBC volume) او ما يعرف (Standard deviation of MCV) هي المسافة تحت الكيرف على ارتفاع (68.2%) من قاعدته (يعني عند الحجم الا يمثله 68% من الخلايا الحمراء)
و منطقيا ايضا كلما زادت المسافه تحت الكيرف نتيجة تباين احجام الخلايا كلما ارتفعت قيمه (RDW-CV)
بكل بساطة قيمة RDW-CVهي نس مئوية للانحراف المعياري لاحجام كرات الدم الحمراء عن الحجم المتوسط MCVو هذه الاكثر شهره في الاستخدام
🤔طيب سؤال ليش ما نقدر نحسبها مانيوال⁉️
بكل بساطة قيمة RDW-CVهي نس مئوية للانحراف المعياري لاحجام كرات الدم الحمراء عن الحجم المتوسط MCVو هذه الاكثر شهره في الاستخدام
🤔طيب سؤال ليش ما نقدر نحسبها مانيوال⁉️
لان القيمة الاحصائية تتطلب وجود عدد كبير من احجام كرات الدم الحمراء و هذا الا بيعمله الجهاز بيقيس حجم كل كرات الدم الحمراء و بالتالي عنده العديد من القيم الا يقدر يحسب بيها البارمتير (RDW) بينما في المانيوال احنا بنحسب متوسط احجام كل كرات الدم الحمراء كقيمة واحدة و هي (MCV)
🤔طيب هل لو انا بشتغل مانوال هل اقدر اعطي الدكتور انطباع ان في (variation) فى احجام الخلايا⁉️
اكيد طبعا وهذا بيتم خلال فحص فيلم الدم ومن المعروف ان حجم كرة الدم الحمراء الطبيعي يساوي حجم نواه لمفوسيت صغيرة و بالتالي طالما عرفت الحجم الطبيعي اقدر بالفحص اشوف هل فى خلايا اكبر فى
اكيد طبعا وهذا بيتم خلال فحص فيلم الدم ومن المعروف ان حجم كرة الدم الحمراء الطبيعي يساوي حجم نواه لمفوسيت صغيرة و بالتالي طالما عرفت الحجم الطبيعي اقدر بالفحص اشوف هل فى خلايا اكبر فى
الحجم او خلايا اصغر فى الحجم مع الخلايا الطبيعية
و لو فعلا موجود نكتب تعليق على الحالة (RBCs anisopoikilocytosis)
و بمعنى ان في (variation) فى احجام و اشكال كرات الدم يعني كأني بقول ان (RDW) عالي
🤔طيب ايش فائدة (RDW) او كيف بتستخدمها⁉️
(RDW) تستخدم للحكم الاولي او المبدئي على
و لو فعلا موجود نكتب تعليق على الحالة (RBCs anisopoikilocytosis)
و بمعنى ان في (variation) فى احجام و اشكال كرات الدم يعني كأني بقول ان (RDW) عالي
🤔طيب ايش فائدة (RDW) او كيف بتستخدمها⁉️
(RDW) تستخدم للحكم الاولي او المبدئي على
نوع الانيميا الموجودة
فمثلا الحالات (microcytic) و المصاحب لها (RDW) مرتفع ترجح ان الحالة (iron deficancy anemia) حيث ان نقص الحديد يحدث على مراحل و بالتالي حنلافي ان في خلايا صغيرة الحجم مصنعة اثناء نقص الحديد بينما يوجد خلايا اخرى اقدم منها طبيعيةالحجم مصنعة وقت ما كان مستوى
فمثلا الحالات (microcytic) و المصاحب لها (RDW) مرتفع ترجح ان الحالة (iron deficancy anemia) حيث ان نقص الحديد يحدث على مراحل و بالتالي حنلافي ان في خلايا صغيرة الحجم مصنعة اثناء نقص الحديد بينما يوجد خلايا اخرى اقدم منها طبيعيةالحجم مصنعة وقت ما كان مستوى
الحديد مناسب و لذلك فهناك (variation) ادى الى ارتفاع (RDW)
على العكس فى حالات (thalassemia) الا فيها ايضا (microcytosis) لكن احجام كل الخلايا صغيرة و متساوية الحجم تقريبا (لان المشكلة هنا جينيه فالتصنيع من البداية واحد)
على العكس فى حالات (thalassemia) الا فيها ايضا (microcytosis) لكن احجام كل الخلايا صغيرة و متساوية الحجم تقريبا (لان المشكلة هنا جينيه فالتصنيع من البداية واحد)
و بالتالي لا يوجد (variation) و (RDW) بتكون بصورة طبيعية
كل الشكر لدكتور خالد مجدي على الشرح فبارك الله به وبعلمه ☺️🙏🏻
كل الشكر لدكتور خالد مجدي على الشرح فبارك الله به وبعلمه ☺️🙏🏻
جاري تحميل الاقتراحات...